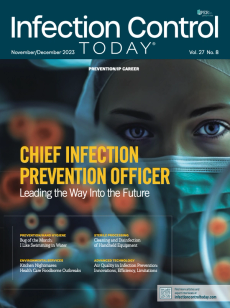
Infection Control Today, November/December 2023 (Vol. 27 No. 8)

Infection Control Today

Infection Control Today, November/December 2025 (Vol. 29 No.6)
Volume: 29
Issue: 6

Infection Control Today, September/October 2025 (Vol. 29 No. 5)
Volume: 29
Issue: 5

Infection Control Today, July/August 2025 (Vol. 29 No.4)
Volume: 29
Issue: 4

Infection Control Today, May/June 2025 (Vol. 29 No.3)
Volume: 29
Issue: 3

Infection Control Today, March/April 2025 (Vol. 29 No.2)
Volume: 29
Issue: 2

Infection Control Today, January/February 2025 (Vol. 29 No.1)
Volume: 29
Issue: 1

Infection Control Today, November/December 2024 (Vol 28 No. 6)
Volume: 28
Issue: 6

Infection Control Today, September/October 2024 (Vol 28 No. 5)
Volume: 28
Issue: 5

Infection Control Today, July/August 2024 (Vol 28 No.4)
Volume: 28
Issue: 4

Infection Control Today, May/June 2024 (Vol. 28 No.3)
Volume: 28
Issue: 3

Infection Control Today, March/April 2024 (Vol.28 No. 2)
Volume: 28
Issue: 2

Infection Control Today, January/February 2024 (Vol. 28 No. 1)
Volume: 28
Issue: 1
Infection Control Today, November/December 2023 (Vol. 27 No. 8)
Volume: 27
Issue: 8

Infection Control Today, September/October 2023 (Vol. 27 No. 7)
Volume: 27
Issue: 7

Infection Control Today, July/August 2023 (Vol. 27 No 6)
Volume: 27
Issue: 6

Infection Control Today, June 2023, (Vol. 27 No. 5)
Volume: 27
Issue: 5

Infection Control Today, May 2023, (Vol. 27, No. 4)
Volume: 27
Issue: 4

Infection Control Today, April 2023, (Vol. 27, No. 3)
Volume: 27
Issue: 3

Infection Control Today, March 2023, (Vol. 27, No. 2)
Volume: 27
Issue: 2

Infection Control Today, January/February 2023, (Vol. 27, No. 1)
Volume: 27
Issue: 1

Infection Control Today, December 2022, (Vol. 26, No. 10)
Volume: 26
Issue: 10

Infection Control Today, November 2022, (Vol. 26, No. 9)
Volume: 26
Issue: 9

Infection Control Today, October 2022, (Vol. 26, No. 8)
Volume: 26
Issue: 8

Infection Control Today, September 2022, (Vol. 26, No. 7)
Volume: 26
Issue: 7

Infection Control Today, July-August 2022, (Vol. 26, No. 6)
Volume: 26
Issue: 6

Infection Control Today, June 2022, (Vol. 26, No. 5)
Volume: 26
Issue: 5

Infection Control Today, May 2022, (Vol. 26, No. 4)
Volume: 26
Issue: 4

Infection Control Today, April 2022, (Vol. 26, No. 3)
Volume: 26
Issue: 3

Infection Control Today, March 2022, (Vol. 26, No. 2)
Volume: 26
Issue: 2

Infection Control Today, January/February 2022, (Vol. 26, No. 1)
Volume: 26
Issue: 1
Advertisement
Advertisement
Trending on Infection Control Today
1
Bug of the Month: The Quiet Guest in the Dust
2
Manual Cleaning vs Automation: Achieving Consistent Cleanliness for Ultrasound Device Reprocessing
3
Continuous Photohydrolysis Disinfection Cuts MDROs, COVID-19, and Hospital Transfers in Long-Term Care, Study Finds
4
Influenza D and Canine Coronavirus: Why Underrecognized Animal Viruses May Be the Next Respiratory Threat
5
